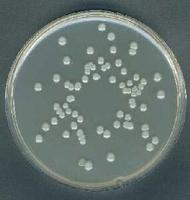
李斯特氏菌
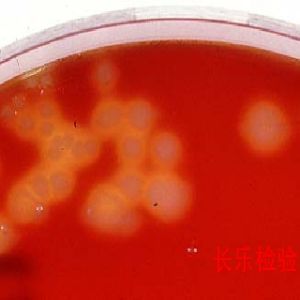
單核細胞增多性李斯特菌

概況
李斯特菌
李斯特菌李斯特菌(也稱李氏桿菌)引起的急性傳染病,以敗血病為主要症狀,伴有內臟器官和中樞神經系統病變。李斯特菌是1926年英國南非裔科學家穆里在病死的兔子體內首次發現的,為紀念近代消毒手術之父、英國生理學家約瑟夫·李斯特(1827~1912),1940年被第三屆國際微生物學大會命名為李斯特菌。
單核細胞增生李斯特氏菌是一種人畜共患病的病原菌。它能引起人畜的李氏菌的病,感染後主要表現為敗血症、腦膜炎和單核細胞增多。它廣泛存在於自然界中,食品中存在的單增李氏菌對人類的安全具有危險,該菌在4℃的環境中仍可生長繁殖,是冷藏食品威脅人類健康的主要病原菌之一,因此,在食品衛生微生物檢驗中,必須加以重視。
李斯特菌在環境中無處不在,在絕大多數食品中都能找到李斯特菌。肉類、蛋類、禽類、海產品、乳製品、蔬菜等都已被證實是李斯特菌的感染源。李斯特菌中毒嚴重的可引起血液和腦組織感染,很多國家都已經採取措施來控制食品中的李斯特菌,並制定了相應的標準。
菌株
 桿狀細菌李斯特菌
桿狀細菌李斯特菌目前國際上公認的李斯特菌共有七個菌株:
1、單核細胞增生李斯特菌(L.monocytohenes)
2、綿羊李斯特菌(L.iuanuii)
3、英諾克李斯特菌(L.innocua)
4、威爾斯李斯特菌(L.innocua)
5、西爾李斯特菌(L.seeligeri)
6、格氏李斯特菌(L.grayi)
7、默氏李斯特菌(L.murrayi)
其中單增李斯特菌是唯一能引起人類疾病的。單核細胞增生李斯特氏菌是一種人畜共患病的病原菌。它能引起人、畜的李氏特菌病,感染後主要表現為敗血症、腦膜炎和單核細胞增多。
特點
 李斯特菌快速檢測試劑盒
李斯特菌快速檢測試劑盒1、分布廣:存在於土壤、水域(地表水、污水、廢水)、昆蟲、植物、蔬菜、魚、鳥、野生動物、家禽。
2、生存環境可塑性大:能在2-42℃下生存(也有報導0℃能緩慢生長)能在冰櫃冷藏室內較長時間生長繁殖。
3、適應範圍大:酸性、鹼性條件下都適應。
4、帶菌較高的食品有:牛奶和乳製品;肉類(特別是牛肉);蔬菜;沙拉;海產品;冰淇凌等。
生存環境
 產單核細胞李斯特菌在半固體培養基上生長情況
產單核細胞李斯特菌在半固體培養基上生長情況李斯特菌在環境中無處不在,在絕大多數食品中都能找到李斯特菌。肉類(非常是牛肉)、蛋類、禽類、海產品、乳製品、蔬菜以及冰淇淋等,都已被證實是李斯特菌的感染源。
李斯特菌具有較強的反抗力,秋冬時期在土壤中能存活5個月以上,在冰塊內也可存活3~5個月,許多冷凍肉類都是它的“溫床”。這種細菌對高溫的反抗力也比較強,能在100℃下挺15~30分鐘,在70℃下可存活30分鐘以上。
單增李斯特氏菌廣泛存在於自然界中,不易被凍融,能耐受較高的滲透壓,在土壤、地表水、污水、廢水、植物、青儲飼料、爛菜中均有該菌存在,所以動物很容易食入該菌,並通過口腔-糞便的途徑進行傳播。據報導,健康人糞便中單增李氏菌的攜帶率為0.6-16%,有70%的人可短期帶菌,4-8%的水產品、5-10%的奶及其產品、30%以上的肉製品及15%以上的家禽均被該菌污染。人主要通過食入軟乳酪、未充分加熱的雞肉、未再次加熱的熱狗、鮮牛奶、巴氏消毒奶、冰激凌、生牛排、羊排、捲心菜色拉、芹菜、西紅柿、法式餡餅、凍豬舌等而感染,約占85-90%的病例是由被污染的食品引起的。
該菌可通過眼及破損皮膚、黏膜進入體內而造成感染,孕婦感染後通過胎盤或產道感染胎兒或新生兒,棲居於陰道、子宮頸的該菌也引起感染,性接觸也是本病傳播的可能途徑,且有上升趨勢。
生物學特性
1、形態與染色
 單核細胞增多性李斯特菌鞭毛染色
單核細胞增多性李斯特菌鞭毛染色該菌為革蘭氏陽性短桿菌,大小約為0.5μmх1.0-2.0μm,直或稍彎,兩端鈍圓,常呈V字型排列,偶有球狀、雙球狀,兼性厭氧、無芽胞,一般不形成莢膜,但在營養豐富的環境中可形成莢膜,在陳舊培養中的菌體可呈絲狀及革蘭氏陰性,該菌有4根周毛和1根端毛,但周毛易脫落。
2、培養特性
該菌營養要求不高,在20--25℃培養有動力,穿刺培養2�5天可見倒立傘狀生長,肉湯培養物在顯微鏡下可見翻跟斗運動。該菌的生長範圍為2--42℃(也有報導在0℃能緩慢生長),最適培養溫度為35--37℃,在pH中性至弱鹼性(pH9.6)、氧分壓略低、二氧化碳張力略高的條件下該菌生長良好,在pH3.8�4.4能緩慢生長,在6.5% NaCl 肉湯中生長良好。在固體培養基上,菌落初始很小,透明,邊緣整齊,呈露滴狀,但隨著菌落的增大,變得不透明。在5-7%的血平板上,菌落通常也不大,灰白色,刺種血平板培養後可產生窄小的β-溶血環。在0.6%酵母浸膏胰酪大豆瓊脂(TSAYE)和改良Mc Bride(MMA)瓊脂上,用450角入射光照射菌落,通過解剖鏡垂直觀察,菌落呈蘭色、灰色或蘭灰色。
3、生化反應
 電子顯微鏡下的單核細胞增多性李斯特菌
電子顯微鏡下的單核細胞增多性李斯特菌該菌觸酶陽性,氧化酶陰性,能發酵多種糖類,產酸不產氣,如發酵葡萄糖、乳糖、水楊素、麥芽糖、鼠李糖、七葉苷、蔗糖(遲發酵)、山梨醇、海藻糖、果糖,不發酵木糖、甘露醇、肌醇、阿拉伯糖、側金盞花醇、棉子糖、衛矛醇和纖維二糖,不利用枸櫞酸鹽,40%膽汁不溶解,吲哚、硫化氫、尿素、明膠液化、硝酸鹽還原、賴氨酸、鳥氨酸均陰性,VP、甲基紅試驗和精氨酸水解陽性。
4、血清型
根據菌體(O)抗原和鞭毛(H)抗原,將單增李氏菌分成13個血清型,分別是1/2a、1/2b、1/2c、3a、3b、3c、4a、4b、4ab、4c、4d、4e 和“7”13 個血清型。致病菌株的血清型一般為1/2b、1/2c、3a、3b、3c、4a、1/2a和4b,後兩型尤多。
5、抵抗力
該菌對理化因素抵抗力較強,在土壤、糞便、青儲飼料和乾草內能長期存活,對鹼和鹽抵抗力強,60-70℃經5-20min可殺死,70%酒精5min、2.5%石炭酸、2.5%氫氧化鈉、2.5%福馬林20min 可殺死此菌。該菌對青黴素、氨苄青黴素、四環素、磺胺均敏感。
致病性
 澳洲食物中毒引發高度關注
澳洲食物中毒引發高度關注單增李斯特菌進入人體是否得病與菌量和宿主的年齡免疫狀態有關,因為該菌是一種細胞內寄生菌,宿主對它的清除主要靠細胞免疫功能,因此,易感者為新生兒、孕婦、40歲以上的成人,免疫功能缺陷者。
潛伏期
在感染後3-70天出現症狀,健康成人可出現輕微類似流感症狀,易感者突然發熱,劇烈頭痛、噁心、嘔吐、腹瀉、敗血症、腦膜炎、孕婦出現流產。
病性機理
單增李氏菌的抗原結構與毒力無關,它的致病性與毒力機理如下:
1、寄生物介導的細胞內增生,使它附著及進入腸細胞與巨噬細胞;
2、抗活化的巨噬細胞,單增李氏菌有細菌性過氧化物歧化酶,使它能抗活化巨噬細胞內的過氧物(為殺菌的毒性游離基團)分解;
3、溶血素,即李斯特桿菌溶血素O,可以從培養物上清液中獲得,為SH活化的細胞溶素,有α和β兩種,為毒力因子。
臨床表現
單核細胞增多性李斯特菌
單核細胞增多性李斯特菌健康成人個體出現輕微類似流感症狀,新生兒、孕婦、免疫缺陷患者表現為呼吸急促、嘔吐、出血性皮疹、化膿性結膜炎、發熱、抽搐、昏迷、自然流產、腦膜炎、敗血症直至死亡。
控制
單增李斯特氏菌在一般熱加工處理中能存活,熱處理已殺滅了競爭性細菌群,使單增李斯特氏菌在沒有競爭的環境條件下易於存活,所以在食品加工中,中心溫度必須達到70℃持續2分鐘以上。單增李斯特氏菌在自然界中廣泛存在,所以即使產品已經過熱加工處理充分滅活了單增李斯特氏菌,但有可能造成產品的二次污染,因此蒸煮後防止二次污染是極為重要的。由於單增李斯特氏菌在4℃下仍然能生長繁殖,所以未加熱的冰櫃食品增加了食物中毒的危險。冰櫃食品需加熱後再食用。
檢驗
1、增菌培養
 1. 將未開封的測試片貯藏在<= 8 oC (46 oF)的環境下,並在包裝上標示的有效期內使用。在高濕度的地方,最好在使用前將測試片回復到室溫。
1. 將未開封的測試片貯藏在<= 8 oC (46 oF)的環境下,並在包裝上標示的有效期內使用。在高濕度的地方,最好在使用前將測試片回復到室溫。取回的樣品應在4℃下處理、存放和運送,如果是冷凍樣品,則在檢驗前要保持冷凍狀態。
取25mL液體或25g半固體或固體樣品放入含有225mL無選擇性試劑增菌肉湯(EB)的均質杯中進行均質,然後轉入三角瓶中,30℃培養4h,加入選擇性試劑吖啶黃素、萘啶酮酸和放線菌酮,繼續培養20h和44h.。
2、分離
共培養24h和48h後,取EB培養物分別在OXA和LPM或加七葉苷/Fe3 LPM瓊脂平板上劃線。PALCAM瓊脂可替代LPM瓊脂。將OXA和PALCAM平板置於35℃培養24-48h,LPM平板在30℃培養24-48h。然後,把LPM平板放於解剖鏡載物台上,以450角入射光從平板下面照射平板,通過目鏡垂直向下觀察尋找可疑菌落。李斯特氏菌在LPM平板上呈有光澤的蘭色或灰色。用已知陽性菌和陰性菌劃線的平板作對照。
 2. 已開封的測試片,將開口反折,用膠帶封好。
2. 已開封的測試片,將開口反折,用膠帶封好。加入七葉苷和Fe3 的LPM平板不用斜射光系統,選擇可疑菌落的方法與在OXA上選擇可疑菌落的方法相同。在OXA平板上李斯特氏菌菌落周圍有一個黑色環,其它菌也可形成黑色環,但形成時間要在兩天以上。李斯特氏菌在PALCAM和OXA平板上的菌落特徵相似。
在PALCAM和OXA或LPM平板上挑取5個或更多的典型菌落,分別劃線於TSAYE平板上以得到更純、更典型的單個菌落。食品檢驗中在TSAYE平板上純化是必須的,因為在PALCAM和OXA或LPM平板上分離菌落時可能沾有不可見的受抑微生物。挑取5個典型菌落的原因是一個樣品中可能分離到一種以上的李斯特氏菌。30℃TSAYE平板培養24-48h,如果不用於動力觀察,也可在35℃培養。
3、鑑定步驟
 3. 為防止暴露於潮濕的環境中,請不要冷藏已開封的測試片。將膠帶封好的測試片貯藏在低溫乾燥的地方,保持時間不超過1個月。請勿將測試片放在溫度> 25 oC (77 oF)和(或)相對濕度> 50%的環境中。
3. 為防止暴露於潮濕的環境中,請不要冷藏已開封的測試片。將膠帶封好的測試片貯藏在低溫乾燥的地方,保持時間不超過1個月。請勿將測試片放在溫度> 25 oC (77 oF)和(或)相對濕度> 50%的環境中。(1)觀察TSAYE平板通過斜射光觀察,尋找呈蘭灰至蘭色菌落。在TSAYE上用已知菌作對照。
(2)、從30℃或更低溫度下培養的TSAYE平板上挑取典型菌落做成濕玻片在油鏡下觀察。濕玻片用0.85%生理鹽水菌懸液製成。如果菌量太少,菌體黏附於載玻片上而呈現非運動性。李斯特氏菌是細短桿菌,可見輕微的鏇轉及翻滾。與已知的李斯特氏菌的對照相比,球形、大的桿狀且快速泳動的都不是李斯特氏菌。
(3)挑取典型菌落進行過氧化氫酶實驗,李斯特氏菌呈過氧化氫酶陽性反應。
(4)取16-24h的培養物進行革蘭氏染色,李斯特氏菌呈革蘭氏陽性桿菌。但是陳舊培養物革蘭氏染色會發生變化,而且菌體可成球形。在染色過重的玻片上菌體有呈柵狀排列的趨勢,易誤認為白喉菌而錯判。
